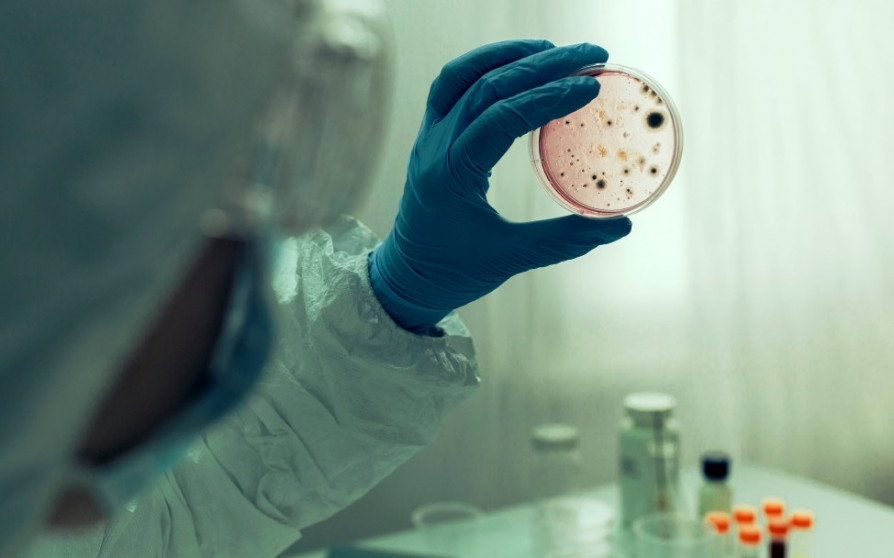

Очікується, що сьогодні санітарно-епідеміологічна інспекція повідомить про результати аналізів проб води, взятих із ряшівського водогону.
«Це була 90-річна мешканка Ряшева, яка померла минулої доби в Підкарпатському центрі легеневих захворювань», ‒ повідомив речник Університетської клінічної лікарні в Ряшеві Анджей Срока.
«Пацієнтка з чисельними захворюваннями потрапила до лікарні кілька днів тому. Це вже п’ята жертва легіонельозу в Університетській клінічній лікарні імені Фридерика Шопена в Ряшеві. Поступив теж новий хворий. Загалом у лікарні перебувають 29 пацієнтів, хворих на легіонельоз», ‒ додав він.
Дані станом на 28 серпня про кількість осіб, інфікованих легіонельозом на Підкарпатті, ще не відомі. 27 серпня повідомлялося, що госпіталізовано 143 людини. Очікується, що сьогодні санітарна інспекція повідомить про результати аналізів проб води, взятих із ряшівського водогону.
Легіонельоз ‒ гостре інфекційне захворювання, яке викликає здебільшого бактерія Legionella pneumophila, рідше інші легіонели. Характеризується поліморфізмом клінічних симптомів із переважним ураженням дихальної системи